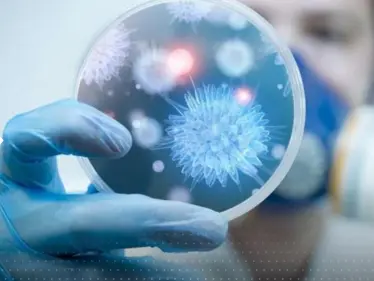
تقرير أمريكي "رفعت عنه السرّية" يكشف مصدر فيروس كورونا - وكالة ستيب نيوز

- نشطاء يعتدون على ماكرون
ظهر في الفيديو المتداول، هجوم النشطاء على ماكرون مع توجيه اتهام له بالتقصير في ملف المناخ، مما استدعى طاقم الأمن للرئيس الفرنسي للتدخل بسرعة وإبعادهم. https://twitter.com/Step_Agency/status/1629850943729594371?s=20 وأثارت ردة فعل حراس الأمن للرئيس الفرنسي غضباً واسعاً، إذ وصف المتابعون طريقة تعامل حراس الأمن مع منفذي الهجوم بـالـ"وحشية".وهذه ليست المرة الأولى التي يتعرض فيها ماكرون للاعتداء، ففي وقتٍ سابقٍ، تعرض للصفع من قبل شخص خلال زيارة له لمنطقة جنوب شرق البلاد، واعتقلت الشرطة شخصين بعد الواقعة.وفي ذلك الوقت، تناقلت وسائل إعلام فرنسية الخبر على نطاق واسع، وأفادت أن السلطات الفرنسية ألقت القبض على شخصين بعدما صفع رجل الرئيس ماكرون على وجهه خلال جولة مع حشد من الناس في منطقة دروم بجنوب شرقي فرنسا. نشطاء يعتدون على ماكروناقرأ أيضا:))ماكرون يتوعد روسيا بـ"حرب طويلة" داعياً أوروبا للاستعداد ويكشف عن 4 مجالات فشلت فيها موسكو بأوكرانيا )) الكشف عن قصة حبّ منذ الحرب العالمية الثانية.. وابنة العاشق تتدخل -صور